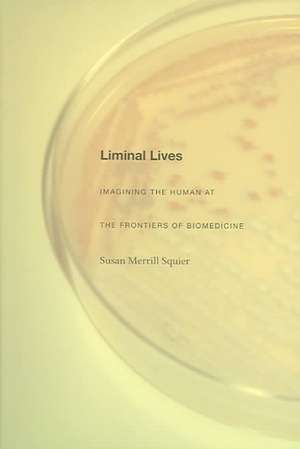
Liminal Lives de Susan Merrill Squier

Liminal Lives
Autor Susan Merrill Squieren Limba Engleză Paperback – 7 dec 2004
Preț: 262.26 lei
Preț vechi: 276.06 lei
-5%
Puncte Express: 393
Carte tipărită la comandă
Livrare economică 05-19 august
Livrare prin curier în România Termenul estimat este afișat lângă disponibilitate.
Transport gratuit de la 400.00 lei Plată online sau ramburs, în funcție de opțiunile comenzii.
Retur gratuit în 14 zile Comandă securizată și suport în română.
Specificații
ISBN-13: 9780822333661
ISBN-10: 082233366X
Pagini: 368
Ilustrații: 17 b&w photographs, 24 illustrations
Dimensiuni: 154 x 228 x 28 mm
Greutate: 0.49 kg
Ediția:New.
Editura: Duke University Press
ISBN-10: 082233366X
Pagini: 368
Ilustrații: 17 b&w photographs, 24 illustrations
Dimensiuni: 154 x 228 x 28 mm
Greutate: 0.49 kg
Ediția:New.
Editura: Duke University Press
Cuprins
Introduction: Networking liminality; 1. The uses of literature for feminist science studies: Tracing liminal lives 2. Life and death at Strangeways: The cultured cell 3. The hybrid embryo and xenogenic desire 4. Giant babies: Graphing growth in the early twentieth century 5. Incubabies and rejuvenates: The traffic between technologies of reproduction and age-extension 6. Transplant medicine and transformative narrative 7. Liminal performances of aging: From replacement to regeneration Coda: The pluripotent discourse of stem cells: Liminality, literature and reflexivity
Recenzii
Susan Squiers Liminal Lives is compelling, timely, imaginative, and wonderfully provocative. Priscilla Wald, author of Constituting Americans: Cultural Anxiety and Narrative Form
Textul de pe ultima copertă
""Liminal Lives" offers very strong and important theoretical insights into relationships between scientific knowledge and practice and literary production. Its innovative methodology creates possibilities for better communication and exchange between scientific, literary, and social scientific knowledge in a way that will be very useful to others interested in interdisciplinary science studies."--Catherine Waldby, author of "AIDS and The Body Politic: Biomedicine and Sexual Difference"
Descriere
A study of the mutually constituitive relations between Western biomedicine and Ango- American literature in the 20th and early 21st centuries, tracing the interwoven processes by which both fields have transformed the course of human life.